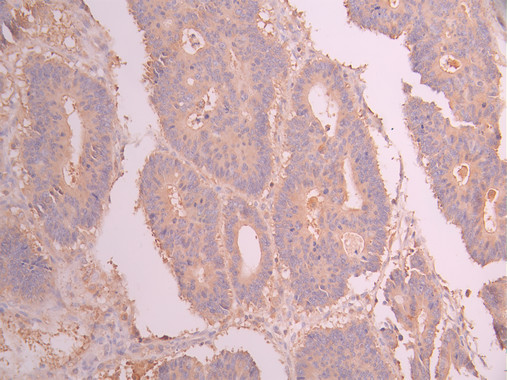

-
中文名稱:GUSB Recombinant Monoclonal Antibody
-
貨號:CSB-RA576809A0HU
-
規格:¥1320
-
圖片:
-
Western Blot
Positive WB detected in: THP-1 whole cell lysate(30μg), U-251MG whole cell lysate(30μg), A431 whole cell lysate(30μg), HeLa whole cell lysate(30μg), HepG2 whole cell lysate(30μg)
All lanes: GUSB antibody at 1:1000
Secondary
Goat polyclonal to rabbit IgG at 1/40000 dilution
Predicted band size: 75 kDa
Observed band size: 78 kDa
Exposure time:3min -
IHC image of CSB-RA576809A0HU diluted at 1:100 and staining in paraffin-embedded human colorectal cancer performed on a Leica BondTM system. After dewaxing and hydration, antigen retrieval was mediated by high pressure in a citrate buffer (pH 6.0). Section was blocked with 10% normal goat serum 30min at RT. Then primary antibody (1% BSA) was incubated at 4°C overnight. The primary is detected by a Goat anti-rabbit polymer IgG labeled by HRP and visualized using 0.05% DAB.
-
IHC image of CSB-RA576809A0HU diluted at 1:100 and staining in paraffin-embedded human liver tissue performed on a Leica BondTM system. After dewaxing and hydration, antigen retrieval was mediated by high pressure in a citrate buffer (pH 6.0). Section was blocked with 10% normal goat serum 30min at RT. Then primary antibody (1% BSA) was incubated at 4°C overnight. The primary is detected by a Goat anti-rabbit polymer IgG labeled by HRP and visualized using 0.05% DAB.
-
Immunofluorescence staining of MCF-7 cell with CSB-RA576809A0HU at 1:50, counter-stained with DAPI. The cells were fixed in 4% formaldehyde, permeabilized using 0.2% Triton X-100 and blocked in 10% normal Goat Serum. The cells were then incubated with the antibody overnight at 4°C. The secondary antibody was Alexa Fluor 488-congugated AffiniPure Goat Anti-Rabbit IgG(H+L).
-
Overlay Peak curve showing 786-O cells stained with CSB-RA576809A0HU (red line) at 1:100. The cells were fixed in 4% formaldehyde and permeated by 0.2% TritonX-100 for 10min. Then 10% normal goat serum to block non-specific protein-protein interactions followed by the antibody (1ug/1*106cells) for 45min at 4℃. The secondary antibody used was FITC-conjugated goat anti-rabbit IgG (H+L) at 1/200 dilution for 35min at 4℃.Control antibody (green line) was Rabbit IgG (1ug/1*106cells) used under the same conditions. Acquisition of >10,000 events was performed.
-
-
其他:
產品詳情
-
Uniprot No.:
-
基因名:
-
別名:Beta-glucuronidase (EC 3.2.1.31) (Beta-G1), GUSB
-
反應種屬:Human
-
免疫原:A synthesized peptide from human GUSB protein
-
免疫原種屬:Homo sapiens (Human)
-
標記方式:Non-conjugated
-
克隆類型:Monoclonal
-
抗體亞型:Rabbit IgG
-
純化方式:Affinity-chromatography
-
克隆號:11D12
-
濃度:It differs from different batches. Please contact us to confirm it.
-
保存緩沖液:Preservative: 0.03% Proclin 300
Constituents: 50% Glycerol, 0.01M PBS, PH 7.4 -
產品提供形式:Liquid
-
應用范圍:ELISA, WB, IHC, IF, FC
-
推薦稀釋比:
Application Recommended Dilution WB 1:500-1:2000 IHC 1:50-1:200 IF 1:50-1:200 FC 1:50-1:200 -
Protocols:
-
儲存條件:Upon receipt, store at -20°C or -80°C. Avoid repeated freeze.
-
貨期:Basically, we can dispatch the products out in 1-3 working days after receiving your orders. Delivery time maybe differs from different purchasing way or location, please kindly consult your local distributors for specific delivery time.
-
用途:For Research Use Only. Not for use in diagnostic or therapeutic procedures.
相關產品
靶點詳情
-
功能:Plays an important role in the degradation of dermatan and keratan sulfates.
-
基因功能參考文獻:
- Results show that GUS mRNA changes in blood are significantly correlated with gait step length variability in premutation (PM) females patients with fragile X tremor ataxia syndrome . PMID: 27387142
- We produced GUS from a CHO cell line grown in suspension in a 15 L perfused bioreactor and developed a three step purification procedure that yields approximately 99% pure enzyme with a recovery of more than 40%. PMID: 28734840
- Selective and amplified bG expression together with the prodrug DOXGA3 had an increased antitumor effect, showing great potential for prostate cancer therapy. PMID: 26648021
- the use of in silico approaches provided a useful understanding of the effect of single point mutations on the structure-function relationship of GUSBp PMID: 26415878
- the efficacy of a helper-dependent (HD) canine adenovirus (CAV-2) vector harboring a human GUSB expression cassette (HD-RIGIE) in the MPS VII dog brain was tested PMID: 24343103
- This assessment demonstrated that although butyrate dramatically increased beta-glucuronidase production in bioreactors, it adversely impacted the mannose-6-phosphorylation of this lysosomal storage diseasestherapeutic enzyme PMID: 24033810
- expression of CES2, UGTA1A1, and GUSB varies in colorectal pathology tissues and that the expression of CES2 is somewhat related to tumor staging. PMID: 24195516
- GUSB and ATP2B4 have been validated as a reliable gene combination for Cystic Fibrosis Transmembrane Conductance Regulator gene qPCR data normalization. PMID: 22525089
- Liver disease affects the expression of common HKGs; beta-glucuronidase and splicing factor arginine/serine-rich 4 are the most stable HKGs for studies of gene expression in HCV-infected human liver. PMID: 21073651
- beta-glucuronidase mutations are associated with mucopolysaccharidosis type VII PMID: 12522561
- Recombinant adeno-associated virus encoding human GUSB injected into the vitreous humor of young adult MPS VII mice increased GUSB activity and reduced lysosomal distension in regions of the thalamus and tectum PMID: 12716937
- beta glucuronidase present in the synovial fluid of rheumatoid arthritis patients, may contribute to the depletion of glycosaminoglycans from cartilage allowing invasion of synovial cells. PMID: 12905469
- Over-expression of beta-glucuronidase was related to the degree of cancer differentiation, but not to lymph node metastasis. PMID: 14612292
- These results indicate that beta-glucuronidase transport into brain parenchyma in early postnatal life is mediated by the mannose 6-phosphate/insulin-like growth factor II receptor. PMID: 15314220
- The genes GUS and PMM1 are recommended for normalization purposes in gene expression studies of liver tissue from patients with chronic hepatitis. PMID: 18591914
- Study summarized information on the 49 unique, disease-causing mutations determined so far in the GUS gene. PMID: 19224584
顯示更多
收起更多
-
相關疾病:Mucopolysaccharidosis 7 (MPS7)
-
亞細胞定位:Lysosome.
-
蛋白家族:Glycosyl hydrolase 2 family
-
數據庫鏈接:
Most popular with customers
-
-
YWHAB Recombinant Monoclonal Antibody
Applications: ELISA, WB, IHC, IF, FC
Species Reactivity: Human, Mouse, Rat
-
Phospho-YAP1 (S127) Recombinant Monoclonal Antibody
Applications: ELISA, WB, IHC
Species Reactivity: Human
-
-
-
-
-